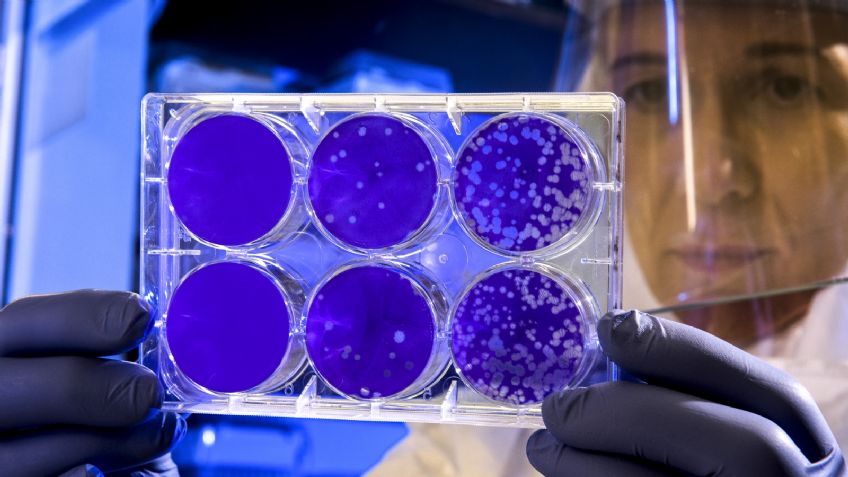
Alerta mundial: Descubren nueva variante de Covid-19 en Francia; presenta 46 mutaciones

París, Francia.- Especialistas informaron que descubrieron una nueva variante del coronavirus al sur de Francia, la cual que se propaga en un pequeño brote, según un nuevo estudio realizado en el país europeo.
Da clic aquí y descubre más información de Tribuna Sonora en nuestra página de Google News
Según los primeros reportes, se cree que la variante llamada B.1.640.2 es de origen camerunés y hasta ahora se ha extendido a 12 pacientes en Francia. Esta variación del virus parece tener 46 nuevas mutaciones y 37 deleciones.
Esta nuevas variantes de Covid-19 fue descubierta a finales del año pasado. Sin embargo, aún no se determina si resulta más peligrosa, ya sea con una tasa de mortalidad más alta o siendo más transmisible.
Solo se sabrá si B.1.640.2 representa un riesgo mayor que la otras variantes a medida que los expertos comprendan mejor cómo funciona. Hay decenas de nuevas variantes descubiertas recientemente, pero eso no significa necesariamente que serán más letales que Delta o Alpha.
Lo que hace que una variante sea más conocida y peligrosa es su capacidad de multiplicarse debido a la cantidad de mutaciones que tiene en relación con el virus original del SARS-CoV-2. Ahí es cuando se convierte en una preocupación, como Ómicron.
Este descubrimiento se produce después de que Francia redujo drásticamente el período de aislamiento para las personas vacunadas en un intento por aliviar la carga financiera y social de la pandemia.
Los tiempos de autoaislamiento para las personas totalmente vacunadas que dan positivo en la prueba bajaron de 10 días a 7 desde el lunes pasado, y se pueden reducir a cinco días si el resultado de la prueba es negativo.
Francia reportó 219 mil 126 nuevas infecciones el pasado sábado y se convirtió en el sexto país del mundo en superar los 10 millones de casos totales registrados de Covid-19.
Fuente: El Financiero